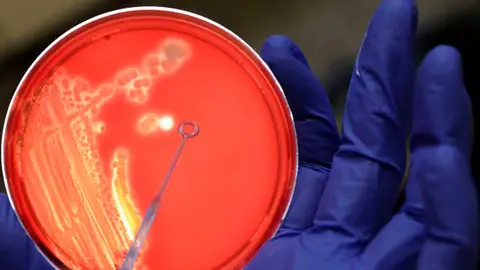
bacterias bacterias

11:17 MIN
Yolanda Sanz: "Un trasplante fecal puede cambiar el comportamiento de una persona"
- 11:17 MIN
Yolanda Sanz: "Un trasplante fecal puede cambiar el comportamiento de una persona"
Hablamos en Más de uno con Yolanda Sanz, investigadora del CSIC y coordinadora del proyecto europeo 'MyNewGut'. Nos descubre la importancia de la microbiota intestinal, factor determinante en nuestro estado de salud y nos explica cómo un trasplante de heces puede ser determinante a la hora de cambiar el comportamiento de una persona. Además, nos explica la importancia del eje intestino-cerebro y nos revela datos tan llamativos como que albergamos al menos un kilo de bacterias en nuestro intestino y que estas influyen en nuestra salud mental.
Hablamos en Más de uno con Yolanda Sanz, investigadora del CSIC y coordinadora del proyecto europeo 'MyNewGut'. Nos descubre la importancia de la microbiota intestinal, factor determinante en nuestro estado de salud y nos explica cómo un trasplante de heces puede ser determinante a la hora de cambiar el comportamiento de una persona. Además, nos explica la importancia del eje intestino-cerebro y nos revela datos tan llamativos como que albergamos al menos un kilo de bacterias en nuestro intestino y que estas influyen en nuestra salud mental.
Temas
- Más de uno
- ciencia
- microbiota



